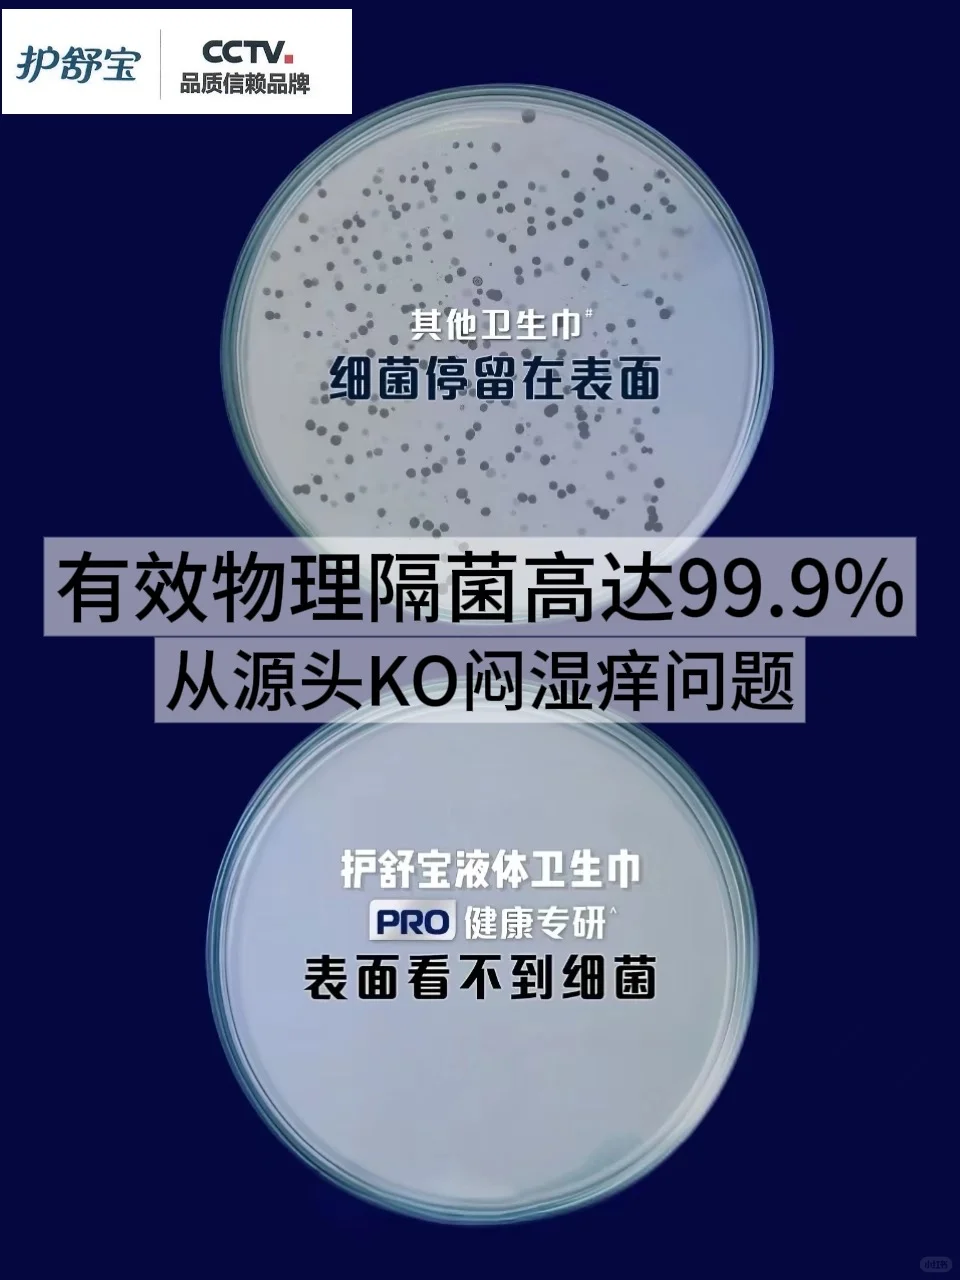

资源爱好者是一个特殊的网站,它喜欢收集各种资源来分享给他人。他们热爱资源,乐于分享,喜欢收集各种资源,以便更好地帮助他人。
CTRL+D收藏本站 - 找资源永不迷路。
物理隔菌级真神❗️新国标后霸榜👑不服不行
作者:Melody 日期:2025-10-19 00:27:52 浏览:3 分类:写真摄影
物理隔菌级真神❗️新国标后霸榜👑不服不行
谁懂啊!生理期的不适真的能把人逼疯!
闷、湿、痒轮番上阵,坐立不安
尤其是年轻那会儿不懂事
跟风试过各种“网红”卫生巾
硬生生把脆弱小花园折腾成了敏感肌!
每次生理期都像渡劫
那种挥之不去的💦潮湿感和随之而来的刺痒
跟无数小蚂蚁在爬似的,简直让人崩溃
☑️后来我才搞明白:原来经期一大半的不舒服
都是卫生巾闷着经血,细菌在底下开party闹的!
.
我那嫁到外国的闺蜜,天天喊着让我给她寄卫生巾
说国外的牌子要么太厚闷得慌
要么添加一堆乱七八糟的东西
她那群外国贵妇朋友
全抢着从国内代购
✨护舒宝液体卫生巾PRO健康专研!
.
用了之后真香了!我就后悔为啥没早点用!
这个护舒宝液体卫生巾PRO健康专研
简直就是KO闷湿痒的“狠角色”
✅99.9%物理隔菌黑科技!纯物理手段安排!
就像在小花园表面盖了一层隐形的“物理隔菌盾”
直接把经血和细菌牢牢锁在底层
细菌连碰都碰不到咱们娇嫩的皮肤!
这一招真的釜底抽薪
从根儿上断了闷湿痒的路子
对我们敏感肌简直不要太友好!
.
上周量最大的那天开了个3小时超长会议
坐的还是那种不透气的皮椅子
以前早就痒得坐立不安了,这次居然没啥感觉!
真的像坐在一团会呼吸的干爽☁️云朵上
不愧是婴儿级别的纤维材质,超级亲肤
舒服到差点忘了自己还在生理期!
👍不愧是连央妈都推荐过的
这份干爽透气带来的安心感,谁用谁懂!
.
建议所有职场姐妹都试试这个宝藏!
不要小看能登🆙口碑榜的尖子生
自从用了它后
我就再也没把眼神分给其他卫生巾了
👏它是真正从根儿上搞定闷湿痒难题!
彻底和\"万蚁噬心\"的痒痒酷刑拜拜
这才是现代女性该有的经期自由啊!
.
#卫生巾推荐 #经期护理 #私护保养推荐 #私处护理 #贵妇卫生巾 #护舒宝 #护舒宝液体卫生巾PRO #护舒宝液体卫生巾PRO健康专研 #物理隔菌卫生巾 #央视十大合格卫生巾
闷、湿、痒轮番上阵,坐立不安
尤其是年轻那会儿不懂事
跟风试过各种“网红”卫生巾
硬生生把脆弱小花园折腾成了敏感肌!
每次生理期都像渡劫
那种挥之不去的💦潮湿感和随之而来的刺痒
跟无数小蚂蚁在爬似的,简直让人崩溃
☑️后来我才搞明白:原来经期一大半的不舒服
都是卫生巾闷着经血,细菌在底下开party闹的!
.
我那嫁到外国的闺蜜,天天喊着让我给她寄卫生巾
说国外的牌子要么太厚闷得慌
要么添加一堆乱七八糟的东西
她那群外国贵妇朋友
全抢着从国内代购
✨护舒宝液体卫生巾PRO健康专研!
.
用了之后真香了!我就后悔为啥没早点用!
这个护舒宝液体卫生巾PRO健康专研
简直就是KO闷湿痒的“狠角色”
✅99.9%物理隔菌黑科技!纯物理手段安排!
就像在小花园表面盖了一层隐形的“物理隔菌盾”
直接把经血和细菌牢牢锁在底层
细菌连碰都碰不到咱们娇嫩的皮肤!
这一招真的釜底抽薪
从根儿上断了闷湿痒的路子
对我们敏感肌简直不要太友好!
.
上周量最大的那天开了个3小时超长会议
坐的还是那种不透气的皮椅子
以前早就痒得坐立不安了,这次居然没啥感觉!
真的像坐在一团会呼吸的干爽☁️云朵上
不愧是婴儿级别的纤维材质,超级亲肤
舒服到差点忘了自己还在生理期!
👍不愧是连央妈都推荐过的
这份干爽透气带来的安心感,谁用谁懂!
.
建议所有职场姐妹都试试这个宝藏!
不要小看能登🆙口碑榜的尖子生
自从用了它后
我就再也没把眼神分给其他卫生巾了
👏它是真正从根儿上搞定闷湿痒难题!
彻底和\"万蚁噬心\"的痒痒酷刑拜拜
这才是现代女性该有的经期自由啊!
.
#卫生巾推荐 #经期护理 #私护保养推荐 #私处护理 #贵妇卫生巾 #护舒宝 #护舒宝液体卫生巾PRO #护舒宝液体卫生巾PRO健康专研 #物理隔菌卫生巾 #央视十大合格卫生巾
猜你喜欢
- 上一篇:不同女生体重的区别对待👀内容过于真实
- 下一篇:赛博减肥哈哈哈哈
- 最近发表